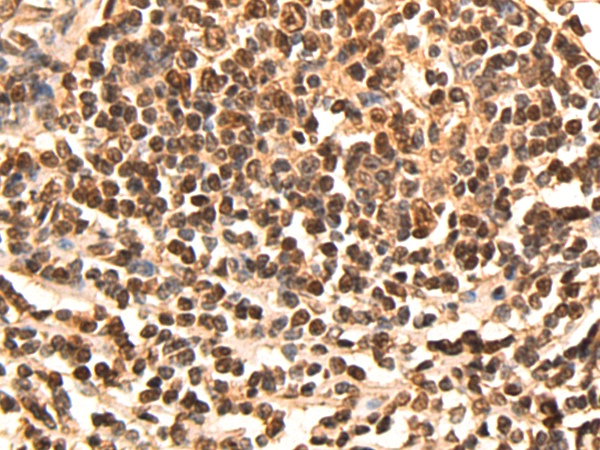
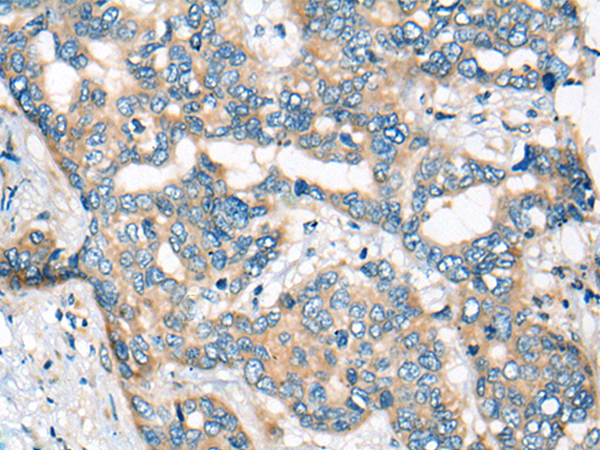
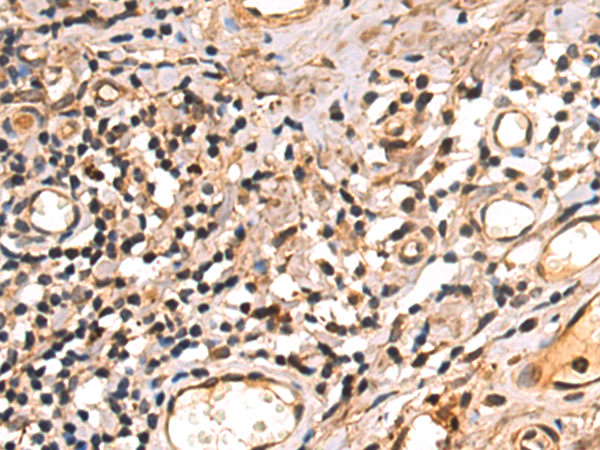

-
分类: 科研抗体货号: P09467别名: SORORIN应用: IHC反应种属: Human
-
分类: 科研抗体货号: P09446别名:应用: IHC反应种属: Human, Mouse
-
分类: 科研抗体货号: P09455别名: ST6N; SIAT1; ST6GalI应用: IHC反应种属: Human, Mouse, Rat
-
分类: 科研抗体货号: P09465别名: Hsk1; CDC7L1; HsCDC7; huCDC7应用: WB反应种属: Human
-
分类: 科研抗体货号: P09445别名: HSPC065应用: IHC反应种属: Human, Mouse
-
分类: 科研抗体货号: P09453别名: T3Z; CD3H; CD3Q; CD3Z; TCRZ; IMD25; CD3-ZETA应用: WB,IHC反应种属: Human, Mouse
-
分类: 科研抗体货号: P09464别名: CEP2; BORG1应用: IHC反应种属: Human, Mouse, Rat
-
分类: 科研抗体货号: P09441别名: hCBR3; SDR21C2; HEL-S-25应用: WB,IHC反应种属: Human, Mouse
-
分类: 科研抗体货号: P09482别名:应用: WB,IHC反应种属: Human, Mouse
-
分类: 科研抗体货号: P09463别名: CDC45L; MGORS7; CDC45L2; PORC-PI-1应用: IHC反应种属: Human, Mouse

鄂公网安备42018502007531号
鄂公网安备42018502007531号

